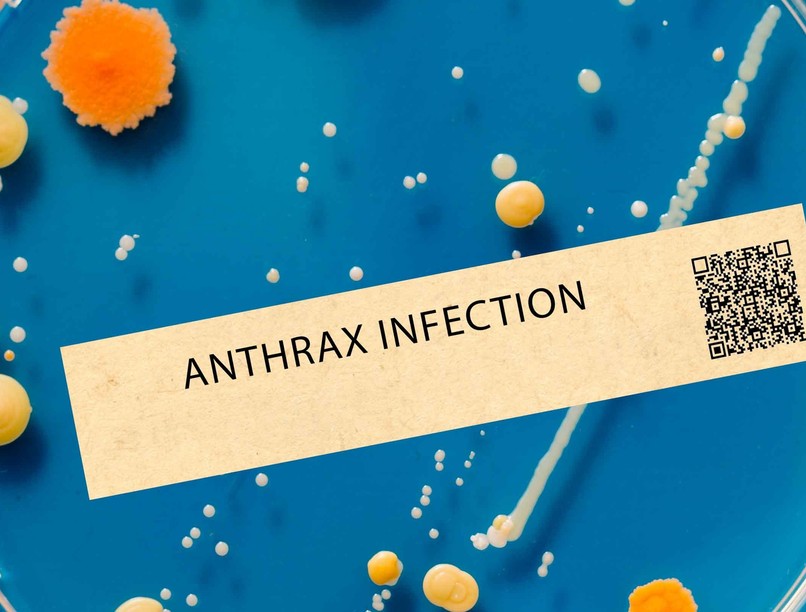
Anthrax (lépfene)

A lépfene (más néven anthrax) akut, néhány formájában magas halálozási aránnyal járó fertőző megbetegedés, melyet a Bacillus anthracis nevű baktérium okoz.
Mintegy száz ismert törzse van a lépfene bacillusnak. Az anthrax az elhullott állatok megnagyobbodott, fekete-barnás elszíneződésű lépéről kapta a nevét. Az anthrax szó a görög anthrakis szóból ered, mely szenet jelent, a bőr bevérző és kifakadó hólyagjai helyén megjelenő pörk (var) fekete színére utalva.
Az anthrax (lépfene) előfordulása

Anthrax (lépfene): tünetei, vizsgálata és a kezelési lehetőségei
Forrás: MTI
A baktérium rendszerint spóra alakban nyugszik a talajban, akár évtizedekig fertőzőképes marad ebben a formában. Amint egy kérődző lenyeli, szaporodni kezd az állatban, és hamarosan megöli.
Az Anthrax rendszerint fertőzött állat húsával vagy egyéb részeivel való érintkezés útján alakul ki. Azok, akik ilyen munkakörben dolgoznak, fokozott kockázatnak vannak kitéve, különösen olyan országokban, ahol a lépfene nem ritka. A szabadban tartott állatok között rendszeresen előfordul a anthrax még a fejlett országokban is. Sokan vannak kitéve munkájuk során mérhető mennyiségű lépfene spórának, de ez a legtöbbször még nem éri el azt a szintet, ami a betegség kialakulásához szükséges.
2006 júliusában egy kezeletlen nyersbőrökkel dolgozó művész volt 30 év óta az első ember Angliában, akinek halálát anthrax okozta. Magyarországon az 1990-es évektől kezdve évente csak egy-két elszigetelt, jól diagnosztizált és sikeresen gyógyított emberi bőranthrax megbetegedést fordult elő, elhullott állatok szállítását is végző állatgondozóknál. Újabban a lépfenebacilus hadászati célra való felhasználás (biológiai hadviselés) miatt került az érdeklődés középpontjába.
Az anthrax (lépfene) okai
A táplálékkal, belélegzéssel és a bőrön keresztül kerülhet a szervezetbe a lépfenebacilus. A behatolási kapunak és a klinikai tüneteknek megfelelően bőr-, tüdő-és bélanthraxot különböztetünk meg. Az anthrax nem ragályos és valószínűtlen, hogy emberről emberre terjed. Az anthrax esetek 95%-ában a fejlődő országokban bőrmanifesztáció jelentkezik, ritka a gyomor-bélcsatornát érintő forma, mely akut has tüneteit produkálja. A pulmonalis anthrax a fertőzések mindössze 5%-a.
Az anthrax (lépfene) tünetei
A bőranthrax gennyes hólyagképződéssel, vizenyősödéssel járó bőrfertőzés, mely a gyorsan kialakuló véráramfertőzés (szepszis) és szövődmények miatt kezelés nélkül halálos kimenetelű.
A bőranthrax típusos megjelenési formája a pustula maligna, mely 1-3 cm nagyságú, s a fertőzést követően 1 nappal kialakuló nekrotizáló, közepén feketévé váló gennyes hólyag, melyet piros udvar, apró hólyagok, és vizenyő vesz körül. Leggyakrabban tenyéren, kézen, arcon, nyakon fordul elő. Többnyire fájdalmatlan. Egy-két hét elteltével az elváltozás beszárad, heggel gyógyul A nyirokutakon keresztül a kórokozók igen gyorsan a véráramba jutnak, és szepszis (vérmérgezés) alakul ki További tünetek: környéki nyirokcsomó-megnagyobbodás, változó láz, fejfájás, hányás.
A pulmonalis forma ritka, de súlyos lefolyású. Két fázisban zajlik le.
- 1 A betegnek néhány napon át a közérzete rossz, elesett, fejfájása van, hőemelkedés, alacsony láz mérhető. Néha szegycsont alatti fájdalomról panaszkodik a beteg. Száraz köhögés, nehéz, -szapora légzés, orr-garat-és gégehurut jelentkezik.
- 2 A második fázis során hirtelen rosszullét, magas láz, véres köpet, mellkasi fájdalom, szeptikus shock jelentkezik, légzési és keringési elégtelenség lép fel és a halál 1-2 nap alatt bekövetkezik.
A bélanthrax ritka kórkép, mely a vékonybél vérzéses, vizenyős gyulladásával jár. Legtöbbször a vakbéltájon, ritkábban a vastagbélben, elvétve a duodenumban telepszik meg. Kezdeti tünetek: hasi fájdalom, émelygés, hányás, elesettség, láz, fejfájás. A fertőzés tovaterjedésével kifejezett lesz a hasi fájdalom, véres székletürítés és véres hányás jelentkezik. A fertőzés a véráram útján máshol is megtelepedhet és súlyos szövődményként szepszist, tüdő- vagy agyhártyagyulladást, halált is okozhat.
Az anthrax (lépfene) lefolyása
Mivel a kezdeti tünetek alapján nehéz a betegséget diagnosztizálni, ezért a halálozás magas. Gyógyszeres kezelés nélkül a bőr-anthrax 20 százalékban halálos kimenetelű. Mindhárom fertőződési fajta következményeként kialakulhat hidegrázással, lázzal, vérzésekkel és keringési zavarokkal kísért agyhártyagyulladás és lépnagyobbodással járó lépfene-szepszis. Mindkét szövődmény halálos kimenetelű, utóbbi nyomán kapta a betegség köznyelvi elnevezését. Az anthrax kezelés nélkül 3-7 nap alatt többnyire halálhoz vezet, de gyors progresszió esetén akár 4-5 nap alatt is bekövetkezhet.
Az anthrax (lépfene) diagnózisa
Az anthrax specifikus diagnózisának alapja a baktérium tenyésztése székletből, a gyomor és bélnedvből és a vérből. Modern géntechnológiai módszerekkel (PCR=polimerase chain reaction) is pár óra leforgása alatt kimutatható. Baktériumok és toxinjaik kimutatása szerológiai módszerekkel is lehetséges.
Az anthrax (lépfene) terápiája
Az anthraxban szenvedő beteg esetlegesen fertőző volta és súlyos szövődményeinek veszélye miatt kórházban kezelendő. A legáltalánosabban használt anthrax elleni antibiotikum a ciprofloxacin. Az antibiotikum kezelés tüdő- és bélanthrax esetén hatvan napig tart. Az antibiotikumok közül penicillint, tetraciklint, eritromicint vagy kloramfenikolt is választhat az orvos. Bőr-anthrax esetén, egy-két héten keresztül intravénás penicillin-kezelést szoktak alkalmazni.
Az anthrax (lépfene) megelőzése
A spóra elpusztításához 5-10 perc forralás vagy két órás 160 fokos száraz hőkezelés szükséges. Az elsődleges megelőzést lényegében az állategészségügyi intézkedések, az állatok rendszeres, lépfene elleni oltása jelenti. Ahol anthrax megbetegedés előfordul, ott antibiotikum profilaxisra van szükség (Ciprofloxacin, Doxicyclin).
Az anthrax elleni humán oltóanyagot 1970 óta használják. Az USA-ban a legveszélyeztetettebb katonai egységeket évek óta oltják, főleg a biológiai fegyverként alkalmazható tüdő-anthrax elleni védelem céljából. Az immunizálást összesen hat bőr alá adott oltásból álló oltási sorozattal végzik. Az első hármat kéthetenként adják be, majd 6, 12 és 18 hónap elteltével további három oltás következik. Utána évenkénti emlékeztető oltás ajánlott, amennyiben szükség van rá.
A tüdő-anthrax, illetve az anthrax-spóra belégzése ellen egyszerű papírmaszkkal lehet védekezni.
Egyéb tudnivalók az anthraxról
Katonai fegyverré való kifejlesztésével viszonylag régóta próbálkoznak, ehhez módosított baktériumtörzseket is használnak. 2001-ben, az USA-ban felmerült a gyanúja, hogy merényletként fehér por alakban helyeztek volna anthrax-spórát levélküldeményekbe.
Hogyan ismerhetők fel korán a lépfene tünetei?
A betegség sikeres kezelése nagyban függ attól, milyen hamar ismeri fel az orvos a lépfene első jeleit. Mivel ritka és gyakran más, hétköznapi betegségekhez hasonlítanak a kezdeti tünetek, fontos figyelni a kórelőzményre: volt-e az érintett személy kapcsolatban állatokkal, bőrrel, gyapjúval, nyers bőrrel, földdel vagy porral? A bőranthrax esetén a fájdalmatlan fekete pörk megjelenése a kulcsjel: ez ugyanis nagyon jellemző és ritka más fertőzéseknél. A tüdőanthrax viszont gyakran „influenzaszerű” tünetekkel indul, és sajnos mire a beteg újra orvoshoz kerül, már a halálos szövődmények is kialakulhatnak. Ezért is nevezik ezt a formát „suttogó gyilkosnak”.
Lépfene és a laboratóriumi biztonság
Mivel a Bacillus anthracis spórái igen ellenállóak, a laboratóriumi munkát szigorú előírások mellett végzik. Az ilyen kórokozókat a legmagasabb biztonsági szintet (BSL-3 vagy BSL-4) igénylő laboratóriumokban tárolják és kutatják. A tudományos közösség etikai szabályrendszere szintén hangsúlyosan tiltja az ilyen kórokozók nem megfelelő célú felhasználását – ez különösen fontossá vált a 2001-es, amerikai anthrax-levélmerényletek után, amelyek során öt ember halt meg és több mint húszan megbetegedtek.
Lépfene és az állatvédelem
A lépfene nemcsak közegészségügyi, hanem jelentős állategészségügyi kihívás is. A betegséget be kell jelenteni, a gyanús elhullásokat az állatorvosnak azonnal vizsgálnia kell. A fertőzött állat tetemét tilos boncolni, mozgatni vagy nyílt térben eltemetni, mert ez a spórák szétszóródásához vezethet. A magyar hatóságok (például a Nébih) külön eljárásrend szerint járnak el, amikor lépfene esetet észlelnek: lezárják a területet, fertőtlenítik a környezetet, és megkezdik a karantént.
Lépfene és a klímaváltozás
Érdekes, és talán kevéssé ismert tény, hogy a globális felmelegedés is szerepet játszhat a lépfene újbóli megjelenésében. A szibériai permafroszt (örökfagy) olvadásával olyan, évszázadokkal ezelőtt elhullott rénszarvasok tetemei kerülhetnek felszínre, amelyek a Bacillus anthracis spóráit még mindig hordozzák. Ilyen esemény történt 2016-ban is az oroszországi Jamal-félszigeten, ahol több száz rénszarvas elpusztult, és egy gyermek is életét vesztette lépfene-fertőzésben. Az éghajlatváltozás tehát közvetett módon növelheti a lépfene kitörésének kockázatát bizonyos területeken.
Lépfene és bioterrorizmus: mit tehet a civil lakosság?
Noha a bioterrorizmus lehetősége aggodalomra ad okot, fontos tudni, hogy az anthrax-spórákat rendkívül nehéz nagy mennyiségben diszpergálni úgy, hogy tömeges megbetegedést okozzanak. A hatóságok világszerte szoros ellenőrzést gyakorolnak a potenciálisan veszélyes biológiai ágensek felett. A lakosság védelmére a gyors diagnosztikai eljárások, az azonnali antibiotikumos profilaxis és a meglévő vakcina is rendelkezésre áll. Az amerikai járványügyi hivatal (CDC) részletes forgatókönyveket dolgozott ki biológiai támadás esetére, amelyek alapján gyorsan lehet reagálni egy fertőzésgyanús helyzetben.
Lépfene a modern vakcinakutatás fókuszában
Az elmúlt években az mRNS-alapú vakcinatechnológia fejlődése lehetőséget nyújtott arra, hogy új, célzottabb lépfene elleni vakcinák is fejlesztés alatt álljanak. A cél az, hogy ne csak a katonai, hanem a civil szférában is gyorsan elérhető és hatékony védelmet biztosító oltások szülessenek. Az NIH Vaccine Research Center és más kutatóintézetek már dolgoznak olyan újgenerációs oltóanyagokon, amelyek biztonságosabbak és kevesebb adaggal is hatékony immunválaszt váltanak ki.
Gyakori kérdések az anthraxról
Emberről emberre fertőzhet-e a lépfene?
Nem jellemző. Az anthrax nem tartozik a klasszikusan emberről emberre terjedő fertőzések közé. A baktérium spórái főként fertőzött állatból, állati termékekből vagy a környezetből kerülnek az ember szervezetébe. Bár az elméleti lehetősége fennáll a bőranthrax közvetlen kontaktus útján való átvitelére, ilyen esetről ritkán számolnak be, és a való életben nem tekinthető jelentős terjedési módnak.
Mennyire veszélyes az anthrax?
A veszélyesség elsősorban a fertőzés típusától függ. A bőranthrax kezeléssel szinte mindig gyógyítható, kezelés nélkül azonban 20% körüli a halálozási arány. A tüdőanthrax és a bélanthrax jóval súlyosabb, gyakran már akkor is életveszélyes, mire a diagnózis megszületik. Ezeknél a formáknál az időben megkezdett antibiotikumos kezelés életet menthet, de a halálozási arány még így is magas, akár 50–80% is lehet késői felismerés esetén.
Létezik-e hatékony védőoltás ellene?
Igen, létezik emberi felhasználásra kifejlesztett oltóanyag, amit főleg a magas kockázatnak kitett csoportok (például laboratóriumi dolgozók, katonák, állat-egészségügyi személyzet) kapnak. Az USA-ban az Anthrax Vaccine Adsorbed (AVA) nevű oltóanyagot használják, hat adagból álló sorozatban. Jelenleg nem tartozik a lakosság számára rutinszerűen ajánlott oltások közé. A vakcina megelőzésre szolgál, nem gyógyításra.
Miért tartják biológiai fegyvernek?
A Bacillus anthracis spórái extrém mértékben ellenállók, a levegőbe porlasztva hosszú ideig fertőzőképesek maradnak. Egy ilyen aeroszolos támadás során tüdőanthrax alakulhatna ki a belélegzett spórák miatt – ez a betegségformák közül a legveszélyesebb. Emellett a spórák előállítása, tárolása és szállítása viszonylag egyszerű (szemben más, instabilabb kórokozókkal), ezért különösen alkalmas bioterrorizmus céljára.
Mi történik, ha valaki lépfenés állattal kerül kapcsolatba?
Az első és legfontosabb lépés az érintett bőrfelület azonnali, bő szappanos lemosása, majd orvosi vizsgálat. Ilyenkor az orvos mérlegeli az antibiotikum-profilaxis szükségességét (jellemzően ciprofloxacint vagy doxiciklint alkalmaznak 60 napon át). Az állati tetemeket ilyenkor nem boncolják, hanem fertőtlenítés után szabályozott módon semmisítik meg. A helyi állategészségügyi hatóságokat haladéktalanul értesíteni kell.
Létezhetnek tünetmentes lépfenefertőzések is?
Igen, különösen bőranthrax esetén előfordulhat, hogy a fertőzés kezdetben észrevétlen marad, vagy enyhe panaszokat okoz. Azonban a betegség gyorsan súlyosbodhat, ezért minden gyanús bőrelváltozást – különösen, ha állattal való érintkezés után alakult ki – érdemes orvossal megvizsgáltatni. A tüdő- és bélformák viszont ritkán maradnak tünetmentesek: ezek gyors lefolyású, súlyos megbetegedések.
Elkapható-e háziállatoktól a betegség?
A háziasított állatok – például kutyák és macskák – ritkán betegednek meg lépfenében, de elméletileg hordozhatják a kórokozót, különösen ha elhullott, fertőzött vadállatokkal érintkeztek. Emiatt fontos, hogy ne engedje házi kedvencét elhullott állati tetem közelébe, különösen erdei séták során. Ha ilyesmi mégis megtörténik, érdemes állatorvoshoz fordulni.
Anthrax társulhat megnagyobbodott nyirokcsomókkal?
Igen, az Anthrax gyakran társulhat megnagyobbodott nyirokcsomókkal. A bőrön keresztül szerzett anthrax esetén a fertőzés helyéhez közeli nyirokcsomók gyakran megduzzadnak és érzékennyé válhatnak. Ez a baktérium helyi terjedésére és az immunrendszer válaszára vezethető vissza. Belégzéses vagy egyéb súlyos formákban a mellkasi vagy más nyirokcsomók érintettsége is előfordulhat.
Kövesse az Egészségkalauz cikkeit a Google Hírek-ben, a Facebook-on, az Instagramon vagy a X-en,Tiktok-on is!